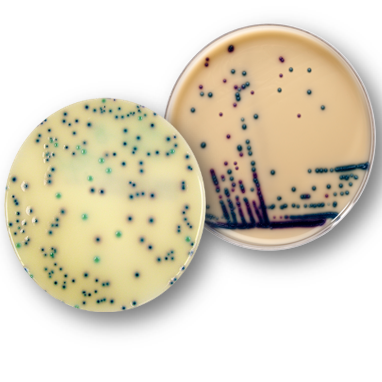

The Liofilchem® MIC Test Strips is a quantitative assay for determining the Minimum Inhibitory Concentration (MIC) of antimicrobial agents against microorganisms to indicate appropriate patient treatment and for identifying resistance patterns.
Liofilchem® MIC Test Strips are made of special high quality paper impregnated with a predefined concentration gradient of antibiotic, across 15 two-fold dilutions like those of a conventional MIC method.
Paper strips* for determining the Minimum Inhibitory Concentration (M.I.C.)